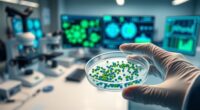
current hearing stem cell research

Recent pharmacological advances focus on protecting your inner ear from ototoxic damage by targeting hair cells and reducing oxidative stress. Researchers are developing innovative drug delivery systems like nanoparticles and intratympanic injections to guarantee effective delivery. Combining these with early detection biomarkers and personalized strategies maximizes protection. Overcoming challenges like genetic susceptibility and translating findings into clinical practice is ongoing. Explore further to discover how these breakthroughs could improve hearing preservation and treatment options for you.
Key Takeaways
- Emerging drug delivery systems like nanoparticles enhance targeted inner ear protection against ototoxic agents.
- Biomarker identification allows for early detection and personalized prevention strategies.
- Pharmacological agents aim to neutralize free radicals and reinforce hair cell resilience during ototoxic exposure.
- Optimized timing and dosing, including pre-, during, and post-exposure administration, improve protective efficacy.
- Clinical trials focus on dose safety, efficacy, and patient compliance to translate advances into practical treatments.

Bright Nutrition Inner-Ear Balance 120 Capsules
Inner Ear Solution with Authentic Herbal Formula
As an affiliate, we earn on qualifying purchases.
As an affiliate, we earn on qualifying purchases.
Understanding the Mechanisms Behind Ototoxicity

Understanding how ototoxic agents damage the ear is essential for developing effective prevention strategies. These agents primarily target the inner ear, specifically the delicate hair cells responsible for hearing. Once inside, they disrupt cellular mechanisms crucial for cell survival and function. Ototoxic substances can generate reactive oxygen species, leading to oxidative stress that damages cell membranes, mitochondria, and DNA. This cellular damage causes hair cell death, resulting in hearing loss. Additionally, some agents interfere with ion channels and neurotransmitter release, impairing signal transduction. Because the inner ear’s cellular mechanisms are so vital for auditory function, understanding how toxins interact at this level helps researchers identify protective targets. This knowledge forms the foundation for developing pharmacological interventions to prevent or mitigate ototoxicity. Recognizing the importance of oxidative stress in this process highlights potential pathways for therapeutic intervention.

Audien Atom One OTC Hearing Aids – Wireless, Rechargeable, and Comfortable | Clear Sound in a Small, Discreet Design for Seniors & Adults with Hearing Loss
Hear What Matters Most: Hearing isn’t one-size-fits-all. That’s why our adjustable frequency system lets you personalize your sound…
As an affiliate, we earn on qualifying purchases.
As an affiliate, we earn on qualifying purchases.
Emerging Pharmacological Agents for Hearing Protection

Recent advances in pharmacology have introduced promising agents aimed at safeguarding hearing by counteracting the damaging effects of ototoxic substances. These emerging pharmacological agents focus on innovative drug delivery systems to target the inner ear more effectively. Researchers are also prioritizing biomarker identification to detect early signs of ototoxicity, enabling timely intervention. Visualize delivery methods that bypass barriers, such as nanoparticles or intratympanic injections, ensuring precise medication placement. Imagine biomarkers that serve as biological flags, signaling damage before hearing loss occurs. These advances foster personalized approaches, optimizing protective strategies. You might think of agents that neutralize free radicals or reinforce hair cell resilience, all delivered directly where needed. Enhancing understanding of inner ear barriers is crucial for developing more effective delivery methods, bringing hope for preventing irreversible hearing damage with minimal side effects.

SoundGear Instant Fit Industrial Electronic Hearing Protection (1 Pair)
25dB NRR, Suppresses noise at 80dBdB, 8dB of Gain, 100% digital, Recommended for Hunters, Shooters and industrial use
As an affiliate, we earn on qualifying purchases.
As an affiliate, we earn on qualifying purchases.
Strategies for Co-Administration of Protective Drugs

Effective co-administration of protective drugs alongside ototoxic agents requires carefully timed and dosed strategies to maximize hearing preservation. You should focus on optimizing drug delivery methods to guarantee the protective agent reaches the inner ear effectively, minimizing systemic side effects. Timing is vital; administering the protective drug before, during, or immediately after ototoxic exposure enhances its efficacy. Dosage optimization is essential to balance effectiveness with safety, avoiding under- or overdosing. You might consider sustained-release formulations or targeted delivery systems to improve drug bioavailability and reduce variability. By integrating precise drug delivery techniques with carefully calibrated dosages, you can greatly improve the chances of safeguarding hearing while maintaining the therapeutic benefits of the primary ototoxic agent. Additionally, understanding the shelf life of protective agents can help ensure their potency and effectiveness during treatment.
biomarker testing kits for hearing loss
As an affiliate, we earn on qualifying purchases.
As an affiliate, we earn on qualifying purchases.
Challenges and Future Directions in Ototoxicity Prevention

Despite advances in pharmacological strategies, several challenges hinder the widespread prevention of ototoxicity. One major obstacle is the variability caused by genetic susceptibility, which makes some individuals more vulnerable than others. Additionally, environmental factors like noise exposure or concurrent medications complicate prevention efforts. Developing universally effective treatments remains difficult because individual responses differ. Furthermore, translating promising findings into real-world applications faces regulatory and logistical hurdles. To overcome these challenges, future research must focus on personalized approaches that consider genetic and environmental influences, enabling targeted interventions. Incorporating cultural and regional differences into prevention strategies can also improve their effectiveness across diverse populations. Addressing these issues will be critical for advancing ototoxicity prevention and protecting vulnerable populations from hearing loss.
Clinical Trials and Real-World Applications

Translating pharmacological strategies for ototoxicity prevention into clinical trials and real-world settings presents both opportunities and challenges. You need to focus on dose optimization to guarantee medications are effective without causing harm. Carefully calibrated doses improve safety profiles and increase the likelihood of success in broader populations. Additionally, patient compliance plays a vital role; if patients don’t follow prescribed regimens, even the best interventions won’t prevent ototoxicity. Real-world applications demand simplified treatment protocols and clear communication to enhance adherence. Clinical trials help identify ideal doses and assess safety, but translating these findings into practice requires understanding patient behaviors. Improving compliance and fine-tuning doses are essential steps to make pharmacological advances practical and beneficial beyond controlled research environments. Recognizing the importance of dog breeds in understanding genetic variations can also inform personalized approaches to treatment.
Frequently Asked Questions
How Do Genetic Factors Influence Susceptibility to Ototoxicity?
You might wonder how genetic factors influence your susceptibility to ototoxicity. Your genetic predisposition plays a significant role, as certain gene variations can make your inner ear more vulnerable to damage from ototoxic agents. Additionally, gene-environment interactions can amplify this risk, meaning your genetic makeup interacts with environmental factors, like medications, increasing the likelihood of hearing loss. Understanding these factors helps tailor prevention and treatment strategies for individual risks.
Are There Specific Biomarkers for Early Detection of Ototoxic Damage?
Imagine catching a whisper before it turns into a shout—that’s the power of early detection. Researchers are actively exploring biomarker discovery to identify subtle signs of ototoxic damage early on. While no single biomarker is definitive yet, advances are promising, and these indicators could help you spot ear injury before symptoms become noticeable. This proactive approach aims to protect your hearing and maintain your quality of life.
What Are the Potential Side Effects of Pharmacological Otoprotectants?
You might wonder about side effects of pharmacological otoprotectants. These drugs can cause drug interactions, affecting how other medications work, and may lead to long-term risks like hearing loss or inner ear damage if used improperly. Always discuss potential side effects with your healthcare provider, especially if you’re on multiple medications, to guarantee safe use. Monitoring and proper dosing can help minimize these risks effectively.
How Cost-Effective Are Current Ototoxicity Prevention Strategies?
You might wonder about the cost-effectiveness of current ototoxicity prevention strategies. Conducting a thorough cost benefit analysis helps determine their economic feasibility, balancing costs against the benefits of hearing preservation. Although some approaches can be expensive upfront, they often save money long-term by reducing hearing loss-related expenses. Overall, these strategies are becoming more economically feasible as technology advances, making prevention more accessible and affordable for patients and healthcare systems alike.
Can Lifestyle Modifications Reduce the Risk of Ototoxicity?
Imagine standing at the edge of a bustling street, where subtle dangers lurk. You can reduce your risk of ototoxicity by making simple lifestyle changes. Dietary adjustments rich in antioxidants may protect your hearing, while minimizing noise exposure keeps your ears safe. Small choices—like wearing ear protection and eating a balanced diet—can dramatically lower your risk, turning everyday habits into powerful shields against ototoxicity’s silent threat.
Conclusion
By staying informed about new pharmacological advances, you can better protect your hearing against ototoxic agents. Embrace the saying, “Forewarned is forearmed,” as ongoing research and emerging therapies offer hope for effective prevention. While challenges remain, your proactive approach and awareness of clinical developments can make a significant difference in preserving your auditory health. Remember, knowledge is power—equip yourself to navigate the future of ototoxicity prevention confidently.